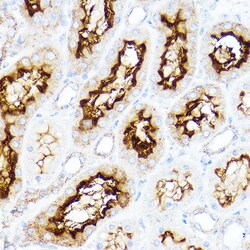
Invitrogen SLC3A1 Polyclonal Antibody 100 &mu;L; Unconjugated:Antibodies,

Learn More
Invitrogen™ SLC3A1 Polyclonal Antibody


Rabbit Polyclonal Antibody
Brand: Invitrogen™ PA596347
Description
Immunogen sequence: LDTVSGNSVY EVITSWMENM PEGKWPNWMI GGPDSSRLTS RLGNQYVNVM NMLLFTLPGT PITYYGEEIG MGNIVAANLN ESYDINTLRS KSPMQWDNSS NAGFSEASNT WLPTNSDYHT VNVDVQKTQP RSALKLYQDL SLLHANELLL NRGWFCHLRN DSHYVVYTRE LDGIDRIFIV VLNFGESTLL NLHNMISGLP AKMRIRLSTN SADKGSKVDT SGIFLDKGEG LIFEHNTKNL LHRQTAFRDR CFVSNRACYS SVLNILYTSC; Positive Samples: HT-29, HepG2, 293T, BxPC-3, PC-12, Mouse liver; Cellular Location: Membrane, Single-pass type II membrane protein.
This gene encodes a type II membrane glycoprotein which is one of the components of the renal amino acid transporter which transports neutral and basic amino acids in the renal tubule and intestinal tract.
Specifications
| SLC3A1 | |
| Polyclonal | |
| Unconjugated | |
| SLC3A1 | |
| amino acid transport related protein; amino acid transporter 1; amino acid transporter SLC3A1; ATR1; b(0,+)-type amino acid transport protein; CSNU1; D2; D2H; FLJ34681; membrane glycoprotein; NAA-TR; Nbat; Neutral and basic amino acid transport protein rBAT; NTAA; rBAT; rBAT protein; si:dkey-202m23.2; Slc3a1; SLC3A1 variant B; SLC3A1 variant C; SLC3A1 variant D; SLC3A1 variant E; SLC3A1 variant F; SLC3A1 variant G; solute carrier family 3 (amino acid transporter heavy chain), member 1; solute carrier family 3 (cystine, dibasic and neutral amino acid transporters), member 1; solute carrier family 3 (cystine, dibasic and neutral amino acid transporters, activator of cystine, dibasic and neutral amino acid transport), member 1; solute carrier family 3 member 1; solute carrier family 3, member 1 | |
| Rabbit | |
| Affinity Chromatography | |
| RUO | |
| 20532, 29484, 6519 | |
| -20°C, Avoid Freeze/Thaw Cycles | |
| Liquid |
| ELISA, Immunohistochemistry (Paraffin), Western Blot | |
| 0.02 mg/mL | |
| PBS with 50% glycerol and 0.02% sodium azide; pH 7.3 | |
| Q07837, Q64319, Q91WV7 | |
| SLC3A1 | |
| Recombinant protein (or fragment). | |
| 100 μL | |
| Primary | |
| Human, Mouse, Rat | |
| Antibody | |
| IgG |
Your input is important to us. Please complete this form to provide feedback related to the content on this product.